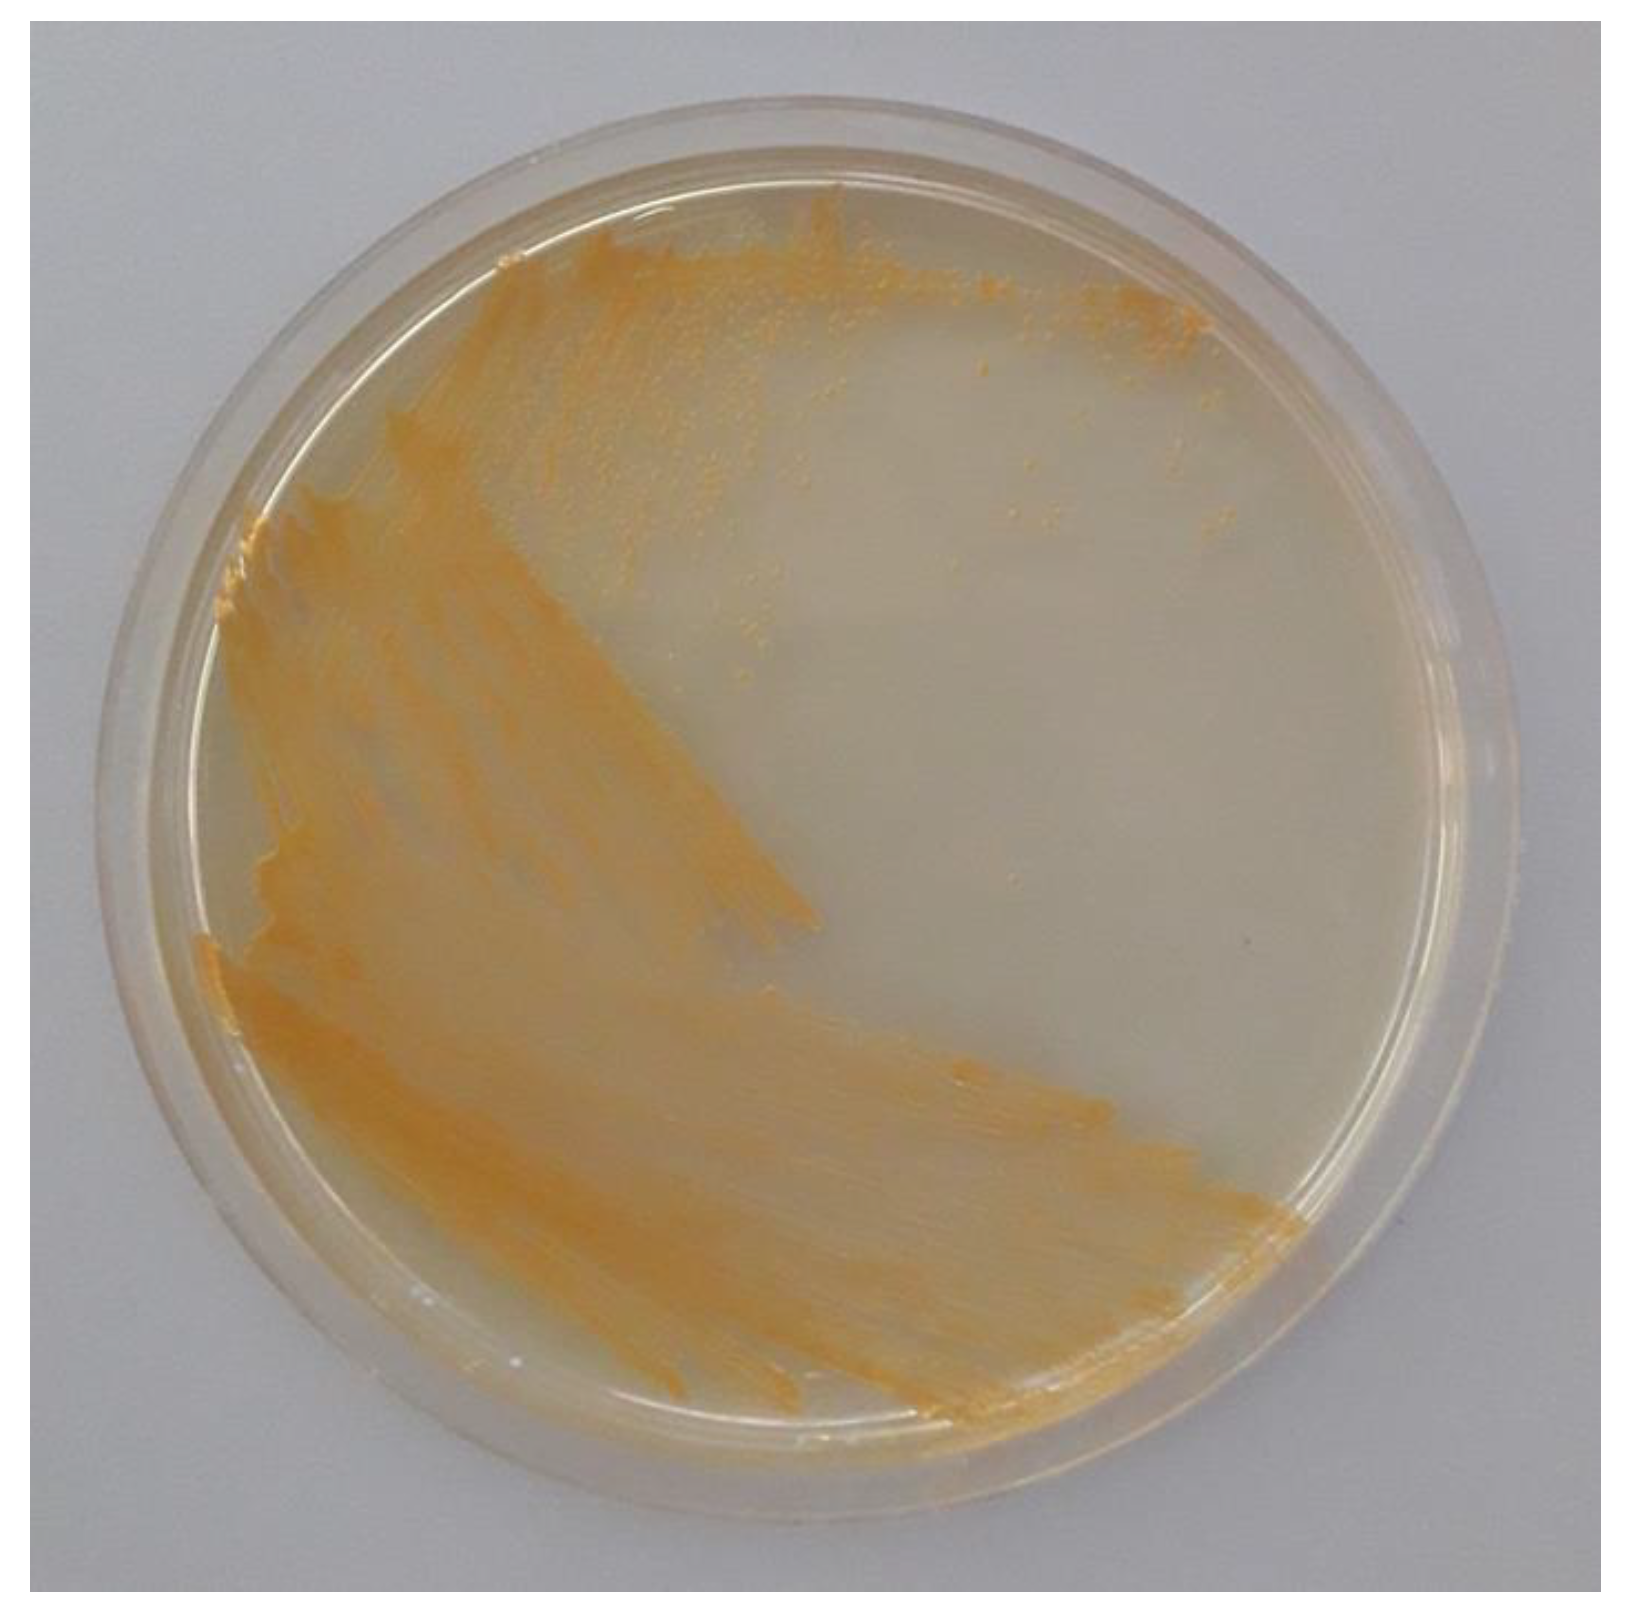
Cosmetics 10 00103 g002

Brevundimonas aurantiaca M3d10, Isolated from the Olive Fly, Produces Hydroxylated Astaxanthin
Abstract
1. Introduction
2. Materials and Methods
2.1. Materials
2.2. Isolation and Molecular Identification of a Carotenoid-Producing Bacterium
2.3. Extraction of Carotenoids
2.4. HPLC Analysis
3. Results and Discussion
3.1. Isolation and Molecular Identification of a Carotenoid-Producing Bacterium
3.2. Identification of Carotenoids
4. Conclusions
Author Contributions
Funding
Institutional Review Board Statement
Informed Consent Statement
Data Availability Statement
Conflicts of Interest
Correction Statement
References
- Aruldass, C.A.; Dufossé, L.; Ahmad, W.A. Current perspective of yellowish-orange pigments from microorganisms—A review. J. Clean. Prod. 2018, 180, 168–182. [Google Scholar] [CrossRef]
- Jannel, S.; Caro, Y.; Bermudes, M.; Petit, T. Novel insights into the biotechnological production of Haematococcus pluvialis -derived astaxanthin advances and key challenges to allow its industrial use as novel food ingredient. J. Mar. Sci. Eng. 2020, 8, 789. [Google Scholar] [CrossRef]
- Davinelli, S.; Nielsen, M.E.; Scapagnini, G. Astaxanthin in skin health, repair, and disease: A comprehensive review. Nutrients 2018, 10, 522. [Google Scholar] [CrossRef] [PubMed]
- Si, P.; Zhu, C. Biological and neurological activities of astaxanthin (Review). Mol. Med. Rep. 2022, 26, 300. [Google Scholar] [CrossRef] [PubMed]
- Nishshanka, G.K.S.H.; Liyanaarachchi, V.C.; Premaratne, M.; Nimarshana, P.H.V.; Ariyadasa, T.U.; Kornaros, M. Wastwater-based microalgal biorefineries for the production of astaxanthin and co-products: Current status, challenges and future perspectives. Biores. Technol. 2021, 342, 126018. [Google Scholar] [CrossRef] [PubMed]
- Zhang, C.; Chen, X.; Too, H.P. Microbial astaxanthin biosynthesis: Recent achievements, challenges, and commercialization outlook. Appl. Microbiol. Biotechnol. 2020, 104, 5725–5737. [Google Scholar] [CrossRef] [PubMed]
- Wan, X.; Zhou, X.R.; Moncalian, G.; Su, L.; Chen, W.C.; Zhu, H.Z.; Chen, D.; Gong, Y.M.; Huang, F.H.; Deng, Q.C. Reprogramming microorganisms for the biosynthesis of astaxanthin via metabolic engineering. Prog. Lipid Res. 2021, 81, 101083. [Google Scholar] [CrossRef]
- Menin, B.; Lami, A.; Musazzi, S.; Petrova, A.A.; Santabarbara, S.; Casazza, A.P. A Comparison of constitutive and inducible non-endogenous keto-carotenoids biosynthesis in Synechocystis sp. PCC 6803. Microorganisms 2019, 7, 501. [Google Scholar] [CrossRef]
- Fang, N.; Wang, C.; Liu, X.; Zhao, X.; Liu, Y.; Liu, X.; Du, Y.; Zhang, Z.; Zhang, H. De novo synthesis of astaxanthin: From organisms to genes. Trends Food Sci. Technol. 2019, 92, 162–171. [Google Scholar] [CrossRef]
- Lu, Q.; Bu, Y.F.; Liu, J.Z. Metabolic engineering of Escherichia coli for producing astaxanthin as the predominant carotenoid. Mar. Drugs 2017, 15, 296. [Google Scholar] [CrossRef]
- Nishida, Y.; Adachi, K.; Kasai, H.; Shizuri, Y.; Shindo, K.; Sawabe, A.; Komemushi, S.; Miki, W.; Misawa, N. Elucidation of a carotenoid biosynthesis gene cluster encoding a novel enzyme, 2,2′-β-hydroxylase, from Brevundimonas sp. Strain SD212 and combinatorial biosynthesis of new or rare xanthophylls. Appl. Environ. Microbiol. 2005, 71, 4286–4296. [Google Scholar] [CrossRef] [PubMed]
- Kanwugu, O.N.; Glukhareva, T.V.; Danilova, I.G.; Kovaleva, E.G. Natural antioxidants in diabetes treatment and management: Prospects of astaxanthin. Crit. Rev. Food Sci. Nutr. 2022, 62, 5005–5028. [Google Scholar] [CrossRef] [PubMed]
- Misawa, N. Carotenoid β-Ring hydroxylase and ketolase from marine bacteria-promiscuous enzymes for synthesizing functional xanthophylls. Mar. Drugs 2011, 9, 757–771. [Google Scholar] [CrossRef]
- Daane, K.M.; Johnson, M.W. Olive fruit fly: Managing an ancient pest in modern times. Annu. Rev. Entomol. 2010, 55, 151–169. [Google Scholar] [CrossRef]
- Marsilio, V.; Campestre, C.; Lanza, B.; De Angelis, M. Sugar and polyol compositions of some European olive fruit varieties (Olea europaea L.) suitable for table olive purposes. Food Chem. 2001, 72, 485–490. [Google Scholar] [CrossRef]
- Capuzzo, C.; Firrao, G.; Mazzon, L.; Squartini, A.; Girolami, V. ‘Candidatus Erwinia dacicola’ a coevolved symbiotic bacterium of the olive fly Bactrocera oleae (Gmelin). Int. J. Syst. Evol. Microbiol. 2005, 55, 1641–1647. [Google Scholar] [CrossRef]
- Ben-Yosef, M.; Aharon, Y.; Jurkevitch, E.; Yuval, B. Give us the tools and we will do the job: Symbiotic bacteria affect olive fly fitness in a diet-dependent fashion. Proc. Royal Soc. B 2010, 277, 1545–1552. [Google Scholar] [CrossRef]
- Powers, E.M. Efficacy of the Ryu nonstaining KOH technique for rapidly determining gram reactions of food-borne and waterborne bacteria and yeasts. Appl. Environ. Microbiol. 1995, 61, 3756–3758. [Google Scholar] [CrossRef]
- Smibert, R.M.; Krieg, N.R. General characterization. In Manual of Methods for General Bacteriology; Gerhardt, P., Murray, R.G.E., Costilow, R.N., Nester, E.W., Wood, W.A., Krieg, N.R., Philips, G.B., Eds.; American Society for Microbiology: Washington, DC, USA, 1981; pp. 411–442. [Google Scholar]
- Han, X.Y. Bacterial identification based on 16S ribosomal RNA gene sequence analysis. In Advanced Techniques in Diagnostic Microbiology; Springer: Boston, MA, USA, 2006. [Google Scholar] [CrossRef]
- Altschul, S.F.; Gish, W.; Miller, W.; Myers, E.W.; Lipman, D.J. Basic local alignment search tool. J. Mol. Biol. 1990, 215, 403–410. [Google Scholar] [CrossRef]
- Asker, D. Isolation and characterization of a novel, highly selective astaxanthin-producing marine bacterium. J. Agric. Food. Chem. 2017, 65, 9101–9109. [Google Scholar] [CrossRef] [PubMed]
- Janda, J.M.; Abbott, S.L. 16S rRNA gene sequencing for bacterial identification in the diagnostic laboratory: Pluses, perils, and pitfalls. J. Clin. Microbiol. 2007, 45, 2761–2764. [Google Scholar] [CrossRef]
- Abraham, W.R.; Stroempl, C.; Meyer, H.; Lindholst, S.; Moore, E.R.B.; Christ, R.; Vancanneyt, M.; Tindall, B.J.; Bennasar, A.; Smit, J.; et al. Phylogeny and polyphasic taxonomy of Caulobacter species. Proposal of Maricaulis gen. nov. with Maricaulis maris (Poindexter) comb. nov. as the type species, and emended description of the genera Brevundimonas and Caulobacter. Int. J. Syst. Bacteriol. 1999, 49, 1053–1073. [Google Scholar] [CrossRef]
- Brownlie, J.C.; Karyn, N.J. Symbiont-mediated protection in insect hosts. Trends Microbiol. 2009, 17, 348–354. [Google Scholar] [CrossRef] [PubMed]
- Dinparast Djadid, N.; Jazayeri, H.; Raz, A.; Favia, G.; Ricci, I.; Zakeri, S. Identification of the midgut microbiota of An. stephensi and An. maculipennis for their application as a paratransgenic tool against malaria. PLoS ONE 2011, 6, e28484. [Google Scholar] [CrossRef] [PubMed]
- Secil, E.S.; Sevim, A.; Demirbag, Z.; Demir, I. Isolation, characterization and virulence of bacteria from Ostrinia nubilalis (Lepidoptera: Pyralidae). Biologia 2012, 67, 767–776. [Google Scholar] [CrossRef]
- Belcari, A.; Sacchetti, P.; Marchi, G.; Surico, G. La mosca delle olive e la simbiosi batterica. Inf. Fitopatol. 2003, 53, 55–59. [Google Scholar]
- Yokoyama, A.; Miki, W.; Izumida, H.; Shizuri, Y. New trihydroxy-keto-carotenoids isolated from an astaxanthin-producing marine bacterium. Biosci. Biotech. Biochem. 1996, 60, 200–203. [Google Scholar] [CrossRef] [PubMed]
- Tao, L.; Rouvière, P.E.; Cheng, Q. A carotenoid synthesis gene cluster from a non-marine Brevundimonas that synthesizes hydroxylated astaxanthin. Gene 2006, 379, 101–108. [Google Scholar] [CrossRef]
- Liu, H.; Zhang, C.; Zhang, X.; Tan, K.; Zhang, H.; Cheng, D.; Ye, T.; Li, S.; Ma, H.; Zheng, H. A novel carotenoids-producing marine bacterium from noble scallop Chlamys nobilis and antioxidant activities of its carotenoid compositions. Food Chem. 2020, 320, 126629. [Google Scholar] [CrossRef]
- Camera, E.; Mastrofrancesco, A.; Fabbri, C.; Daubrawa, F.; Picardo, M.; Sies, H.; Stahl, W. Astaxanthin, canthaxanthin and beta-carotene differently affect UVA-induced oxidative damage and expression of oxidative stress-responsive enzymes. Exp. Dermatol. 2009, 18, 222–231. [Google Scholar] [CrossRef]

Disclaimer/Publisher’s Note: The statements, opinions and data contained in all publications are solely those of the individual author(s) and contributor(s) and not of MDPI and/or the editor(s). MDPI and/or the editor(s) disclaim responsibility for any injury to people or property resulting from any ideas, methods, instructions or products referred to in the content. |
© 2023 by the authors. Licensee MDPI, Basel, Switzerland. This article is an open access article distributed under the terms and conditions of the Creative Commons Attribution (CC BY) license (https://creativecommons.org/licenses/by/4.0/).
Share and Cite
Centini, M.; Martinez-Sañudo, I.; Biagi, M.; Dreassi, E.; Mazzon, L.; Marri, L. Brevundimonas aurantiaca M3d10, Isolated from the Olive Fly, Produces Hydroxylated Astaxanthin. Cosmetics 2023, 10, 103. https://doi.org/10.3390/cosmetics10040103
Centini M, Martinez-Sañudo I, Biagi M, Dreassi E, Mazzon L, Marri L. Brevundimonas aurantiaca M3d10, Isolated from the Olive Fly, Produces Hydroxylated Astaxanthin. Cosmetics. 2023; 10(4):103. https://doi.org/10.3390/cosmetics10040103
Chicago/Turabian StyleCentini, Marisanna, Isabel Martinez-Sañudo, Marco Biagi, Elena Dreassi, Luca Mazzon, and Laura Marri. 2023. "Brevundimonas aurantiaca M3d10, Isolated from the Olive Fly, Produces Hydroxylated Astaxanthin" Cosmetics 10, no. 4: 103. https://doi.org/10.3390/cosmetics10040103
APA StyleCentini, M., Martinez-Sañudo, I., Biagi, M., Dreassi, E., Mazzon, L., & Marri, L. (2023). Brevundimonas aurantiaca M3d10, Isolated from the Olive Fly, Produces Hydroxylated Astaxanthin. Cosmetics, 10(4), 103. https://doi.org/10.3390/cosmetics10040103

